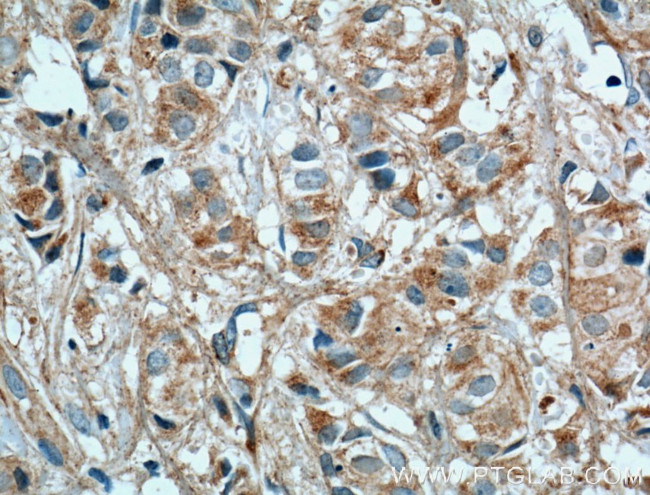
TSKU Antibody in Immunohistochemistry (Paraffin) (IHC (P))

Search
Proteintech
TSKU Polyclonal Antibody
{{$productOrderCtrl.translations['antibody.pdp.commerceCard.promotion.promotions']}}
{{$productOrderCtrl.translations['antibody.pdp.commerceCard.promotion.viewpromo']}}
{{$productOrderCtrl.translations['antibody.pdp.commerceCard.promotion.promocode']}}: {{promo.promoCode}} {{promo.promoTitle}} {{promo.promoDescription}}. {{$productOrderCtrl.translations['antibody.pdp.commerceCard.promotion.learnmore']}}
产品信息
12370-1-AP
种属反应
宿主/亚型
分类
类型
抗原
偶联物
形式
浓度
规格
纯化类型
保存液
内含物
保存条件
运输条件
产品详细信息
Immunogen sequence: MPWPLLLLL AVSGAQTTRP CFPGCQCEVE TFGLFDSFSL TRVDCSGLGP HIMPVPIPLD TAHLDLSSNR LEMVNESVLA GPGYTTLAGL DLSHNLLTSI SPTAFSRLRY LESLDLSHNG LTALPAESFT SSPLSDVNLS HNQLREVSVS AFTTHSQGRA LHVDLSHNLI HRLVPHPTRA GLPAPTIQSL NLAWNRLHAV PNLRDLPLRY LSLDGNPLAV IGPGAFAGLG GLTHLSLASL QRLPELAPSG FRELPGLQVL DLSGNPKLNW AGAEVFSGLS SLQELDLSGT NLVPLPEALL LHLPALQSVS VGQDVRCRRL VREGTYPRRP GSSPKVALHC VDTRDSAARG PTIL (1-353 aa encoded by BC020975)
靶标信息
The TSKU gene encodes Tsukushi, a member of the small leucine-rich proteoglycan (SLRP) family, playing crucial roles in cellular signaling, growth, and development. Tsukushi is characterized by its involvement in various biological processes, including immune regulation, tissue remodeling, and metabolic homeostasis. It is a hepatokine released in response to conditions like nonalcoholic fatty liver disease (NAFLD), influencing metabolic traits and contributing to conditions such as dyslipidemia and cardiovascular diseases. Tsukushi impacts energy expenditure by modulating brown fat thermogenesis, thereby affecting metabolic homeostasis and obesity-related metabolic traits. As an extracellular matrix component, Tsukushi participates in signaling pathways that regulate cell proliferation, migration, and differentiation, impacting organ development and pathophysiological processes. Its role in metabolic and inflammatory diseases presents it as a potential biomarker and therapeutic target in conditions characterized by altered metabolic and inflammatory states. Ongoing research further elucidates Tsukushi's mechanisms and interactions, contributing to our understanding of its multifunctional roles in health and disease.
仅用于科研。不用于诊断过程。未经明确授权不得转售。
篇参考文献 (0)
生物信息学
蛋白别名: E2-induced gene 4 protein; leucine rich repeat containing 54; Leucine-rich repeat-containing protein 54; Tsukushi; tsukushi homolog; tsukushi small leucine rich proteoglycan homolog; tsukushin; unnamed protein product
基因别名: 9530051K01Rik; E2IG4; LRRC54; TSK; TSKU; UNQ850/PRO1788
UniProt ID: (Human) Q8WUA8, (Mouse) Q8CBR6
Entrez Gene ID: (Human) 25987, (Mouse) 244152